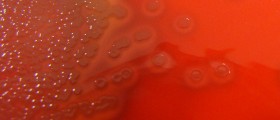

Hi, folks. I know that all should be clean around babies. They are especially sensitive to germs. I would like to know something more about life-threatening in babies. I really need this piece of info, so I will appreciate all your replies considering this. Thank you in advance for all your help.
Loading...
Hello. I think one of the most dangerous life-threatening infections in babies is group B streptococcus (GBS) infections. GBS can give sepsis and meningitis in newborns. GBS can also cause pneumonia. Before developing prevention methods, many newborns died from GBS infections. If they appear, they are usually treated with antibiotics. Penicillin is the antibiotic of choice. Many people are carriers of GBS. It means that they have bacteria, but does not have a disease. They are a potential source of the spreading of bacteria. I hope this helps.
Loading...
Hallo,
Babies are very fragile and they are very prone to infection so you need to take care of your baby as much as you can. The thing is that strep infections are very often in babies. Also baby can suffer from pneumonia, sepsis, meningitis, ear infection and throat infection. These are all caused by bacterial infections. If you notice any of these infection in your baby you need to take her to the doctor’s office to see what can be done to treat the infections. Also E coli is often a problem in newborns which is usually treated with antibiotics. I hope this helped you a bit.
All the best to you,
Karen
Babies are very fragile and they are very prone to infection so you need to take care of your baby as much as you can. The thing is that strep infections are very often in babies. Also baby can suffer from pneumonia, sepsis, meningitis, ear infection and throat infection. These are all caused by bacterial infections. If you notice any of these infection in your baby you need to take her to the doctor’s office to see what can be done to treat the infections. Also E coli is often a problem in newborns which is usually treated with antibiotics. I hope this helped you a bit.
All the best to you,
Karen
Loading...